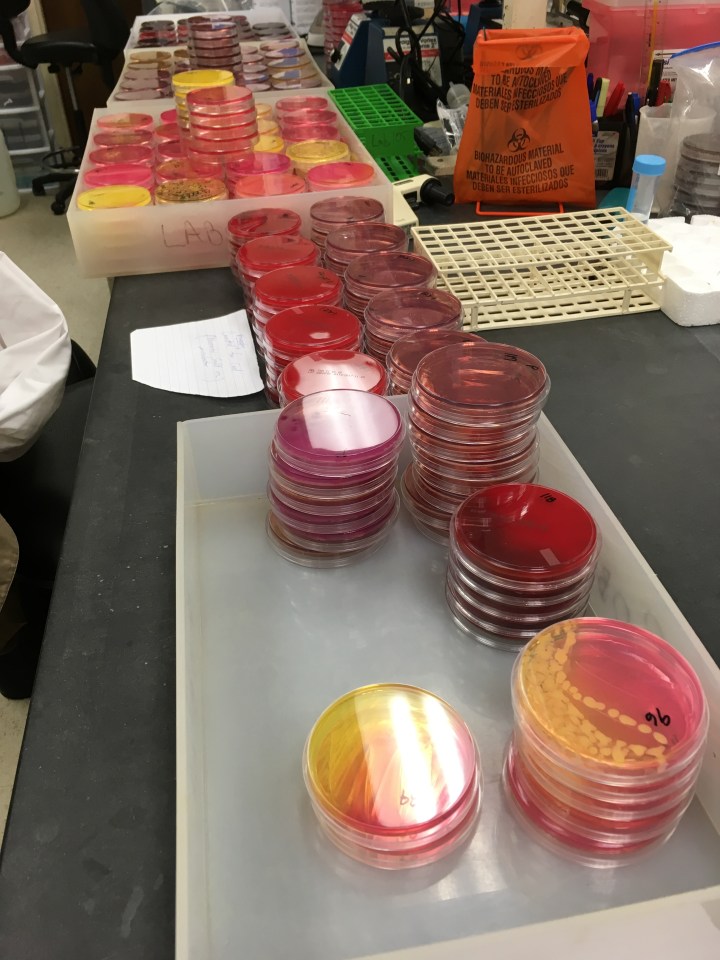

Presentation May 3 in Galveston: “Ship Biscuit & Salted Beef”


Join us on Thursday evening, May 3, at Rosenberg Library in Galveston as Grace Tsai (above at center, with the SBSB team) offers up “Ship Biscuit & Salted Beef: An Experimental Archaeological Study on Shipboard Food.” The Hawkins Squadron business meeting will begin at 1900 hours, with Ms. Tsai’s presentation at 1920. Please note the change of venue; light refreshments will be served.



Before canning and refrigeration were invented, strict limitations on shipboard provisions to reduce illness from food spoilage on ships were enforced. Unfortunately, these preservation methods also decreased the nutritional value of food on lengthy voyages. Grace Tsai’s research looks into the effects of shipboard diet on the health of sailors via the nutritional and microbiological intake of seamen on 17th-century ships. However, rather than using traditional methods to determine past health and nutrition, this project involved replicating shipboard food using the exact ingredients and methods of preparation from the 17th century. This data will support or refute historical accounts related to shipboard food and sailors’ experiences on ships, refine our grasp on our shared maritime history, and create new material for further study in maritime history.

Ms. Tsai graduated with bachelor degrees in Psychology and Anthropology from the University of California, San Diego in 2011. Currently, she is a PhD student in the Nautical Archaeology Program at Texas A&M University. Her work focuses on understanding post-medieval seafaring life through analysis of diet and physical labor on sailors’ health. Her most recent field work includes the Gnaliç Project, an excavation of a sixteenth-century Venetian galley that sank off the coast of Croatia, the Burgaz Harbor Project, an excavation of Hellenistic harbors in Turkey, and the Shelburne Steamboat Project, an excavation of a steamboat graveyard in Vermont. She has also helped catalogue lead fishnet weights from Uluburun, a late Bronze Age shipwreck, in Turkey. In her free time, she works as the co-founder and CEO of Bezoar Laboratories LLC, a R&D company focusing on probiotic supplements.
The Texas Navy Association is a private, 501(c)(3) organization, dedicated to preserving and promoting the historical legacy of the naval forces of the Republic of Texas, 1835-46. The mission of the Texas Navy Association is to preserve and promote an appreciation of the historic character and heroic acts of the Texas Navy; to promote travel by visitors to historical sites and areas in which the Texas Navy operated; to conduct, in the broadest sense, a public relations campaign to create a responsible and accurate image of Texas; and to encourage Texas communities, organizations, and individuals, as well as governmental entities, to participate with actions and money, in pursuit of these objectives. Membership in the Texas Navy Association is open to all persons age 16 and over who have an interest in Texas history and want to help support the goals of the organization.
In Galveston, the Charles E. Hawkins Squadron was organized in the fall of 2016, and meets on the first Thursday evening in odd-numbered months.
________






I proudly supported these efforts at GoFundMe! Huzzah!
Cool research!